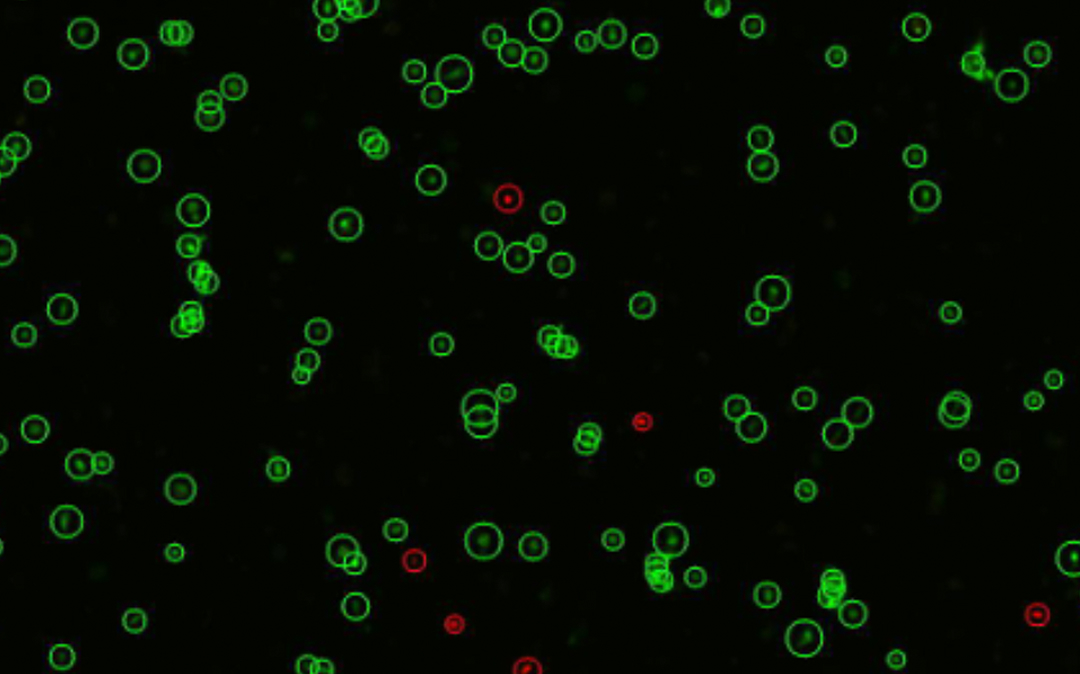

ي”¼ë¶€ ê³ ë¯¼ىک ê·¼ى›گى„ ي•´ê²°ي•کëٹ” 365mc만ىک ي”¼ë¶€ ى¬ىƒ ى†”루ى…کى…니다.
ى§€ë°©ى¤„기ى…€ ىٹ¤ي‚¨ىƒ·ى´ë€?
ë¹›ë‚کëٹ” ê´‘ى±„, يƒ„ë ¥ىˆëٹ” ي”¼ë¶€
ë‚´ ى•ˆىک ىƒëھ…ë ¥ىœ¼ë،œ ي”¼ë¶€ىک ى‹œê°„ى„
ëگکëڈŒë¦½ë‹ˆë‹¤.
ى§€ë°©ى¤„기ى…€ ىٹ¤ي‚¨ىƒ·ى€ LAMSآ·ى§€ë°©ي،ى… ى‹œىˆ ë،œ ى±„ى·¨ي•œ ى§€ë°©ى—گى„œ ى¤„기ى„¸يڈ¬ë¥¼ ى¶”ى¶œي•کى—¬
ي”¼ë¶€ ê³ ë¯¼ى´ ىˆëٹ” 부ىœ„ى—گ ى§پى ‘ ى£¼ى…, ى¬ىƒ ë°ڈ يڑŒë³µى„ ëڈ•ëٹ” ي”„ë،œê·¸ë¨ى…니다.
ى§€ë°© ىœ ëک ى¤„기ى„¸يڈ¬ë¥¼ ى§„ي”¼ى—گ ى§پى ‘ ى£¼ى…ي•کى—¬ ى†گىƒپëگœ ى„¸يڈ¬ë¥¼ ى¬ىƒى‹œي‚´ىœ¼ë،œىچ¨
ي”¼ë¶€ ë…¸ي™” ë°ڈ ىƒپى²کىک ى›گى¸ى„ ي•´ê²°ي•©ë‹ˆë‹¤.



 ى§€ى •
ى§€ى •
â€کى²¨ë‹¨ى¬ىƒىک료 ى‹¤ى‹œê¸°ê´€â€™ى„ ى •
êµê°€ê°€ ى¸ى •ي•œ ى§€ë°©ى¤„기ى„¸يڈ¬ 기ىˆ ë،œ
ي”¼ë¶€ ى†چ ê¹ٹىˆ™ى´ ى¬ىƒىک يکى„ ى „달ي•©ë‹ˆë‹¤.
365mc강남본ى گى€ 기ىˆ ë ¥ ى•ˆى „ى„± ى„¤ë¹„ 기ى¤€ى„ ëھ¨ë‘گ ى¶©ى،±ي•œ ى¸ى¦ 기관ى…니다.
365mcى§€ë°©ى¤„기ى„¸يڈ¬ى„¼ي„°ى—گى„œ ى§„ى§œ ى‚´ى•„ىˆëٹ” ى¤„기ى„¸يڈ¬ë¥¼ ê²½ي—کي•´ë³´ى„¸ىڑ”.


ى§€ë°©ى¤„기ى…€ ىٹ¤ي‚¨ىƒ·ىک يٹ¹ë³„ي•¨
눈ىœ¼ë،œ ë³´ى´ëٹ” ي™•ى‹¤ي•œ ى°¨ى´!
365mcê°€ ë§Œë“ يٹ¹ë³„ي•œ ىٹ¤ي‚¨ى¼€ى–´

2ê°œى›” 경과받ى€ ىھ½
※ ىƒپ기 기ىˆ ëگœ يڑ¨ê³¼ 등ى€ ê°œى¸ى°¨ê°€ ىˆى„ ىˆک ىˆىœ¼ë©°, ê²½ىڑ°ى—گ ë”°ë¼ ë¶€ى‘ىڑ©ى´ ë‚کيƒ€ë‚ ىˆک ىˆىٹµë‹ˆë‹¤
-
ê¹ٹى€ ى¬ىƒë ¥
ى§€ë°©ى¤„기ى„¸يڈ¬ىک ى„±ى¥ى¸ىگê°€
ى§€ë°©ى—گ ىکپى–‘ى„ 공급ي•´
볼륨 ىœ ى§€ë ¥ى´ يƒپى›”ي•©ë‹ˆë‹¤. -
ê· ى¼ي•œ ي”¼ë¶€ ي†¤
ى‹ ىƒ ëھ¨ى„¸يکˆê´€ يک•ى„±ىœ¼ë،œ
يکˆë¥کê°€ ê°œى„ ëگکى–´ ë§‘ê³ ىƒê¸° ىˆëٹ”
ي”¼ë¶€ ي†¤ى„ ëگکى°¾ىٹµë‹ˆë‹¤. -
يƒ„ë ¥آ·ي”¼ë¶€ê²° ê°œى„
ى½œë¼ê²گآ·ى—کë¼ىٹ¤ي‹´ ىƒى„±ى„ ى´‰ى§„ي•´
ى£¼ë¦„ى„ ى™„ي™”ي•کê³
ي”¼ë¶€ê²°ى„ 매ëپˆي•ک게 ي•©ë‹ˆë‹¤. -
ىگى—°ىٹ¤ëں¬ىڑ´ ى ٹىŒ ىœ ى§€
ى‹œê°„ى´ ى§€ë‚ ىˆکë، ي”¼ë¶€ 본ى—°ىک
يکى´ ê°•ي™”ëگکى–´ ىگى—°ىٹ¤ëں½ê³
ىک¤ëکê°€ëٹ” ë³€ي™”를 ى„ ى‚¬ي•©ë‹ˆë‹¤.
※ ىƒپ기 기ىˆ ëگœ يڑ¨ê³¼ 등ى€ ê°œى¸ى°¨ê°€ ىˆى„ ىˆک ىˆىœ¼ë©°,
ê²½ىڑ°ى—گ ë”°ë¼ ë¶€ى‘ىڑ©ى´ ë‚کيƒ€ë‚ ىˆک ىˆىٹµë‹ˆë‹¤
Why 365mc?
ى§€ë°©ى¤„기ى…€
ىٹ¤ي‚¨ىƒ·
ى™œ 365mcى—¬ى•¼ ي• 까ىڑ”?
ى§€ë°©ى „문가 365mcى™€ ëھ¨ë‹›ى…€ىک ë…¸ي•کىڑ°ê°€ ë§Œë“ ê²°ê³¼!
ى œëŒ€ë،œ ëگœ, ى§„ى§œ ى‚´ى•„ىˆëٹ” ى§€ë°©ى¤„기ى„¸يڈ¬ë¼ ىگى‹ ي•©ë‹ˆë‹¤.
ى••ëڈ„ى پى¸ ى¤„기ى„¸يڈ¬ ي•¨ëں‰ى„ ë³´ىœ ي•œ ى§€ë°©!
365mcëٹ” 23ë…„ ى´ىƒپ ى§€ë°© ي•کë‚ک만 ë°”ë¼ë³¸ ى§€ë°©ى „문가ë،œ يکˆى•، آ· 골ىˆک보다 250만배 ë§ژى€ ى§€ë°©ى¤„기ى„¸يڈ¬ë¥¼ 꾸ى¤€يˆ ى—°êµ¬آ·ê°œë°œي•´ى™”ىٹµë‹ˆë‹¤.
ى¶•ى پëگœ ë…¸ي•کىڑ°ë،œ 만ى،±ëڈ„ 높ى€ ى§€ë°©ى¤„기ى„¸يڈ¬ ي”„ë،œê·¸ë¨ى„ ى œê³µي•کê³ ىˆىٹµë‹ˆë‹¤.
ë‚´ ى§€ë°© ى†چ ê°•ë ¥ي•œ ى¬ىƒىک يک
يکˆى•،آ·ê³¨ىˆک보다 250만배 ë§ژى€ ى§€ë°©ى¤„기ى„¸يڈ¬ 그냥 버릴 ى‹¤ ê±´ê°€ىڑ”?
ى œëŒ€يکˆ(يکˆى•،)
0.01개
ë§گى´ˆيکˆ(يکˆى•،)
1개
골ىˆک
46.5개
ى§€ë°©
25,602.6개
골ىˆک 대비 500ë°°
ë§گى´ˆيکˆ 대비 25,000ë°°
ى œëŒ€يکˆ 대비 2,500,000ë°°
* 100만개 ىœ ي•µى„¸يڈ¬ë‹¹ يڈ‰ê· ى¤‘ê°„ى—½ ى¤„기ى„¸يڈ¬ ىˆک
ى¶”ى¶œë¶€ي„° 보관까ى§€ يٹ¹ي—ˆى¶œى›گي•œ 기ىˆ ë،œ ê°•ë ¥ي•ک게!
365mcëٹ” ëŒىٹ¤ / ى§€ë°©ي،ى…, ى¤„기ى„¸يڈ¬ ى¶”ى¶œ, 분리, ë³´ê´€ ى‹œىˆ 까ى§€. يٹ¹ي—ˆى¶œى›گي•œ ê³ ىœ ىک 기ىˆ ى„ ي†µي•´ ê³ ي’ˆى§ˆآ·ê³ ىˆکىœ¨ىک ى§€ë°©ى¤„기ى„¸يڈ¬ë§Œى„ ى•ˆى „ي•ک게 ى œê³µي•©ë‹ˆë‹¤.
ى§„ى§œ ى‚´ى•„ىˆëٹ” ى„¸يڈ¬ëٹ” 높ى€ ىƒى°©ë¥ ê³¼ ê°•ë ¥ي•œ يڑ¨ê³¼ë¥¼ ىگë‘ي•©ë‹ˆë‹¤.
ى••ëڈ„ى پ ى„±ى¥ë¥ ë،œ ëچ” ê°•ë ¥ي•œ ى¬ىƒ يڑ¨ê³¼!
365mcىک ى§€ë°©ى¤„기ى„¸يڈ¬ëٹ” ى„±ى¥ ى†چëڈ„ê°€ ë¹¨ë¼ ى¬ىƒيڑ¨ê³¼ê°€ ë›°ى–´ë‚©ë‹ˆë‹¤. ى´ë،œ ى¸ي•´
ي”¼ë¶€ يƒ„ë ¥ë¶€ي„° ى،°ى§پ ى¬ىƒ, ë…¸ي™” ىکˆë°© 등 ëچ” ى ٹê³ ê±´ê°•ي•œ 미ëک를 يڑ¨ê³¼ى پىœ¼ë،œ ى¤€ë¹„ي• ىˆک ىˆىٹµë‹ˆë‹¤.

ى•ˆى „ي•ک게 ë³´ê´€ëگœ, ى‚´ى•„ىˆëٹ” ى§€ë°©ى¤„기ى„¸يڈ¬ë§Œ ى£¼ى…!
ى„¸يڈ¬ 본ى—°ىک ىƒëھ…ë ¥ى„ 그대ë،œ! 130cc당 1ى–µ ى…€ ى´ىƒپ, ë°°ى–‘ ى—†ى´ ى‚´ى•„ىˆëٹ” ى¤„기ى„¸يڈ¬ë§Œ ë‹´ى•„
높ى€ ىƒى°©ë¥ ê³¼ ë¹ ë¥¸ يڑŒë³µى„ ى´ëپŒى–´ëƒ…니다.

* ى´ˆë،ىƒ‰ : Live cell, 빨간ىƒ‰ : Dead cell
* ى§€ë°© 130cc당
ى§€ë°©ى¤„기ى…€ ىٹ¤ي‚¨ىƒ· ى§„ي–‰ ê³¼ى •
ى¶”ى¶œë¶€ي„° ë³´ê´€, ى‹œىˆ 까ى§€ ي•œ ê³³ى—گى„œ!
ى›گىٹ¤ي†±ى´ë¼ ى•ˆى „ي•کê³ يڑ¨ê³¼ê°€ ë›°ى–´ë‚©ë‹ˆë‹¤.
Process
ي”¼ë¶€ى—گ ى§پى ‘ ى§€ë°©ى¤„기ى„¸يڈ¬ë¥¼ ى£¼ى…ي•کى—¬
ي”¼ë¶€ ى¬ىƒ آ· يƒ„ë ¥ ê°œى„ ى„ ëڈ„ëھ¨ي•©ë‹ˆë‹¤.

ê°œى¸ىک ي”¼ë¶€ ىƒپيƒœى™€ ê°œى„ ëھ©ى پى—گ ë§ى¶° 1:1 ى „문 ىƒپë‹´ى„ ى§„ي–‰ي•©ë‹ˆë‹¤.

365mcىک ë…¸ي•کىڑ°, ëŒىٹ¤ë¥¼ ي†µي•´ ى–‘ى§ˆىک ىگê°€ى§€ë°©ى„ ى•ˆى „ي•ک게 ى±„ى·¨ي•©ë‹ˆë‹¤.

365mc만ىک يٹ¹ي—ˆى¶œى›گ 기ىˆ ى„ ي†µي•´ ىˆœëڈ„ 높ى€ ى§€ë°©ى¤„기ى„¸يڈ¬ë¥¼ ى¶”ى¶œي•©ë‹ˆë‹¤.

ى§€ë°©ى¤„기ى„¸يڈ¬ë¥¼ ي”¼ë¶€ى—گ ى§پى ‘ ى£¼ى…ي•کى—¬ ي”¼ë¶€ ى¬ىƒى„ ى´‰ى§„ي•کê³
يƒ„ë ¥ ê°•ي™”, ê±´ê°•ي•œ ي”¼ë¶€ë¥¼ ى™„ى„±ي•©ë‹ˆë‹¤.

ى‹œىˆ ي›„ ى§„ى •ى„ ëڈ„ى™€ ى£¼ëٹ” يŒ©ê³¼ ى§„ى •ë ˆى´ى ¸ë،œ ى§„ي–‰ى„ ëڈ„ى™€ 드립니다.
ى‹œىˆ ى›گ리
ىٹ¤ي‚¨ë¶€ىٹ¤ي„° ى‹œىˆ ى‹œ, ى£¼ى…ëگœ ى§€ë°©ى¤„기ى„¸يڈ¬ê°€ ى„±ى¥ ى¸ىگ를 분비ي•´ ى½œë¼ê²گê³¼ ى—کë¼ىٹ¤ي‹´ ىƒى„±ى„ ى´‰ى§„ي•کë©° ى‹ ىƒ ëھ¨ى„¸يکˆê´€ يک•ى„±ى„ ىœ ëڈ„ي•©ë‹ˆë‹¤.
ê·¸ ê²°ê³¼ ي”¼ë¶€ 구ى،°ê°€ يڑŒë³µëگکë©° يƒ„ë ¥ ى¦ê°€, ى£¼ë¦„ ى™„ي™”, 미백 등ىک ى¬ىƒ يڑ¨ê³¼ê°€ ë‚کيƒ€ë‚©ë‹ˆë‹¤.







365mc Adipose-derived Stem Cell Center

365mc Adipose-derived Stem Cell Center

365mc Adipose-derived Stem Cell Center

365mc Adipose-derived Stem Cell Center
ى§€ë°©ى¤„기ى„¸يڈ¬ë،œ ى±„ىڑ°ëٹ” ي”¼ë¶€ ى—گ너ى§€!
ىٹ¤ي‚¨ë¶€ىٹ¤ي„°, ى´ëں° 분들ê»ک ى¶”ى²œë“œë¦½ë‹ˆë‹¤.
-
Checkpoint 01.
ىƒê¸° ى—†ê³ ى¹™ى¹™ي•œ ي”¼ë¶€ê°€ ى‹ ê²½ ى“°ى´ëٹ” 분
-
Checkpoint 02.
يƒ„ë ¥ى´ ë–¨ى–´ى§€ê³ ى²کى§€ëٹ” 게 ëٹگê»´ى§€ëٹ” 분
-
Checkpoint 03.
ى—¬ë“œë¦„ ىگêµى´ë‚ک يٹ¸ëں¬ë¸” ي‰ي„°ê°€ ىˆëٹ” 분
-
Checkpoint 04.
ê±´ى،°ي•کê³ ê±°ى¹œ ي”¼ë¶€ê°€ ê³ ë¯¼ى´ى‹ 분
-
Checkpoint 05.
기ى،´ ي”¼ë¶€ê³¼ ى‹œىˆ ى‹œ ى•½ë¬¼ 부ى‘ىڑ©ى´ ىˆى—ˆëچک 분
-
Checkpoint 06.
يƒ„يƒ„ي•کê³ ىƒê¸°ىˆëٹ” ي”¼ë¶€ë¥¼ 계ى†چ ىœ ى§€ي•کê³ ى‹¶ى€ 분
365mc ى„±ê³µê¸°
يگ르ëٹ” ى‹œê°„ ى†چ, 다ى‹œ ي”¼ى–´ë‚œ ى•„름다ى›€!
기ى پê°™ى€ ى´ى•¼ê¸°ë¥¼ ىƒىƒي•œ ي›„기ë،œ 만ë‚کë³´ى„¸ىڑ”.
ï¼ٹىک료법ى—گ ë”°ë¼ ىگى„¸ي•œ ي›„기ëٹ” ë،œê·¸ى¸ ي›„ ي™•ى¸ ê°€ëٹ¥ي•©ë‹ˆë‹¤.




 يٹ¹ي—ˆى¶œى›گ
يٹ¹ي—ˆى¶œى›گ

























